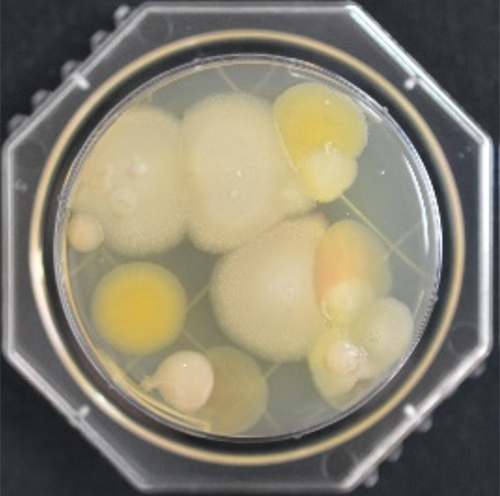

空気を守る水
次亜塩素酸水
ウェルネス空調システムへの応用
室内空気汚染の一つである、かび・細菌などの微生物汚染は人や建物にとって好ましくない環境要因となります。執務空間の健康性向上は、空調設備における新たな課題となっています。
当社では執務空間の快適性と健康性(※WELL Building Standard)の提供を目的として、次亜塩素酸水生成装置(KOGANEI超!おててきれい)を活用した微生物汚染の防止効果について研究を進めています。
- ※WELL BuildingStandard:建築環境が利用者の健康に与える影響としての指標
空調ドレンパンの付着菌の不活化効果
空調ドレンパンなど長時間水分に曝される部分は微生物が繫殖しやすい環境となります。
次亜塩素酸水を活用した場合の効果を検証し、空調システムへの応用方法を開発しています。


実際に運用されている建物での実証実験において、ドレンパンの付着菌数の減少がみられたことから、菌の不活化効果は充分に発揮されていると認められます。
これは、室内環境の微生物汚染の防止とともに、ドレン管の詰り抑制、臭気対策、乾燥スライムの飛散防止等に有効な技術であると期待されます。

不活化効果実験(培養後のコロニー形成状況)


